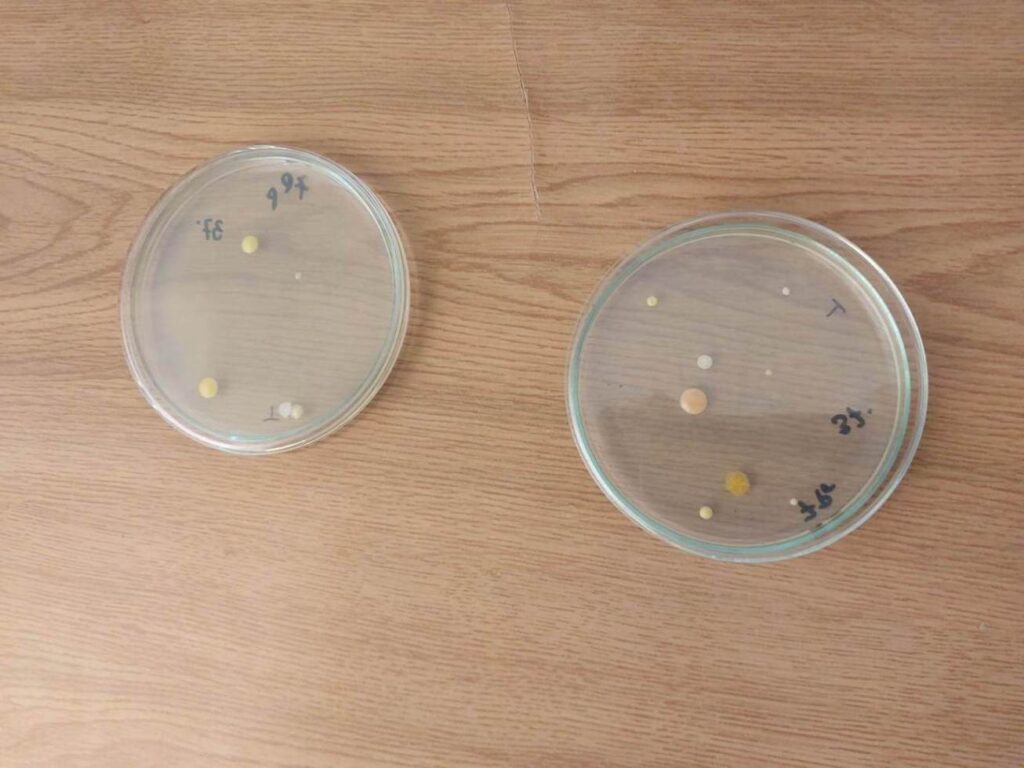
4
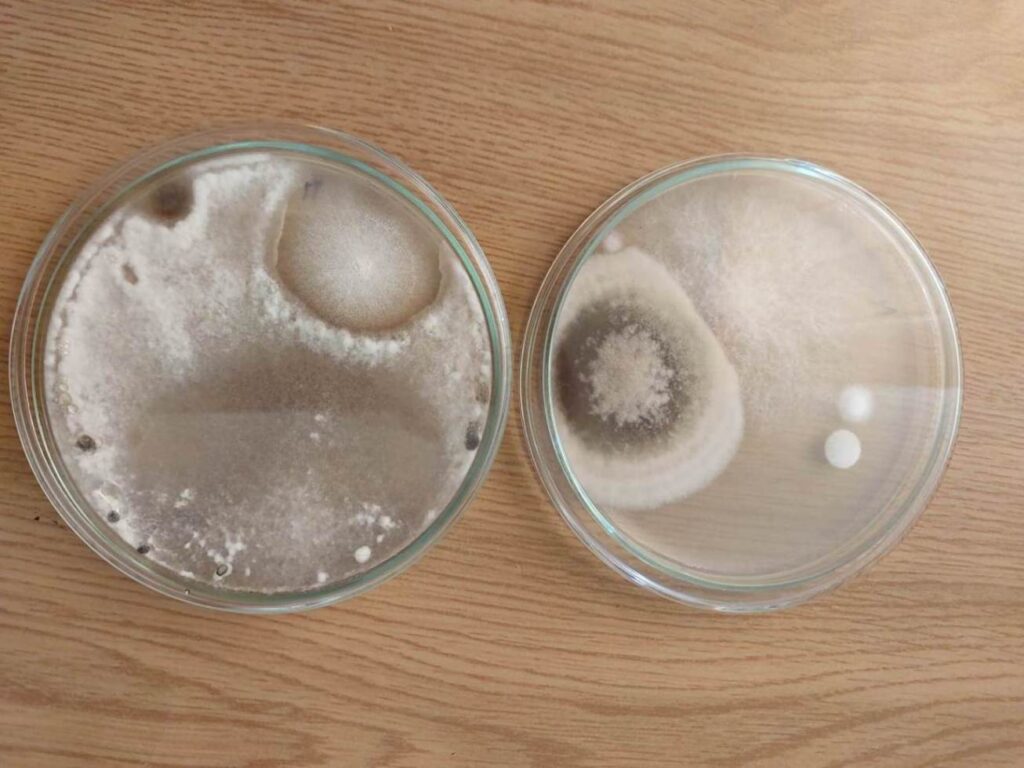
13

26-05-2023 uczniowie z technikum budowlanego wraz z nauczycielami przedmiotów zawodowych budowlanych p. Wacławą Pióro i p. Agnieszką Rycek oraz wicedyrektor Elżbietą Mizio uczestniczyli w warsztatach na Politechnice Lubelskiej na wydziale Inżynierii Środowiska. Młodzież RCEZ przywitała Dziekan prof. dr hab. inż. Beata KOWALSKA.
Zajęcia prowadzone przez dr inż. Sławomirę Dumałę i dr inż. Amelię Staszowską odbywały się w grupach i dotyczyły:
Uczniowie mieli okazję zobaczyć, w jaki sposób działa kamera termowizyjna, gdzie i jak jest wykorzystywana. Sami mogli dokonać pomiarów termowizyjnych. Na warsztatach dotyczących jakości powietrza dowiedzieli się o sposobach prowadzenia badań oraz wykorzystywanych narzędziach. Obserwowali badane próbki oraz poznali konsekwencje zanieczyszczenia powietrza.